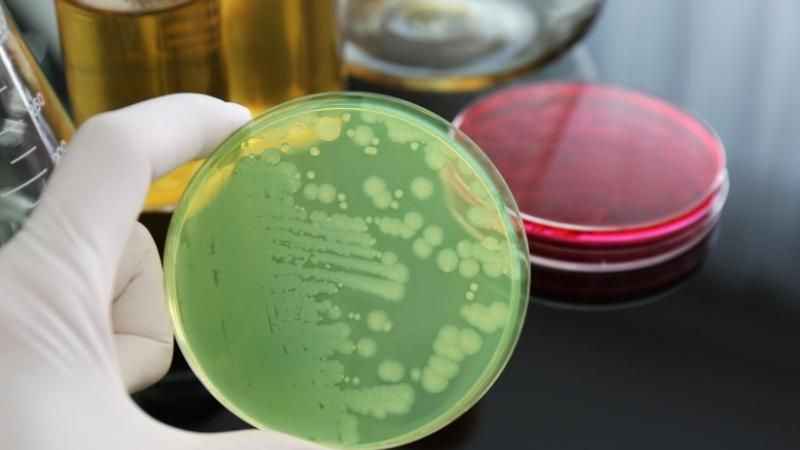

ABD Sağlık ve İnsan Hizmetleri Bakanlığı (HHS), Maryland eyaletinde yaşayan bir kişide “et yiyen” Yeni Dünya vida kurdu (New World screwworm) vakası saptandığını duyurdu.
Söz konusu hastanın kısa süre önce El Salvador’dan ABD’ye döndüğü belirtildi.
HHS sözcüsü Andrew Nixon, bunun ABD’de “bir salgın bölgesinden kaynaklanan ilk insan vakası” olduğuna dikkat çekerek, “Bu vakadan kaynaklanan halk sağlığı riski çok düşük” açıklamasını yaptı.
PARAZİTİN ETKİSİ
ABD Tarım Bakanlığı (USDA), larvaların canlı dokunun içine girerek hızla yayıldığını ve çoğu zaman ölümcül sonuçlara yol açabildiğini vurguladı.
USDA açıklamasında, “Bu kurtçuklar hayvanların etine gömülerek ciddi hasar verir ve nadiren de olsa insanları etkileyebilir” ifadesi kullanıldı.
Uzmanlar, hastalığın “miyazis” adı verilen ve sinek larvalarının insan dokusunda gelişmesiyle ortaya çıkan bir enfeksiyon olduğunu belirtiyor.
ET YİYEN SİNEK NERELERDE GÖRÜLÜYOR?
Yeni Dünya vida kurdu, esas olarak Güney Amerika ve Karayipler’de görülüyor.
Ancak son aylarda Meksika’daki sığır sürülerinde ve bazı çiftçilerde görülen vakalar, ABD’de alarm zillerinin çalmasına neden oldu. Bu gelişmeler üzerine yetkililer, ülkeye girişlerdeki denetimleri artırdı.
Maryland’de tespit edilen son vaka ise 4 Ağustos’ta, “telediagnostik” adı verilen bir yöntemle doğrulandı. Bu süreçte hastadan alınan larva görüntüleri uzmanlarca incelendi. Ancak hastanın sağlık durumuna ilişkin henüz resmi bir açıklama yapılmadı.